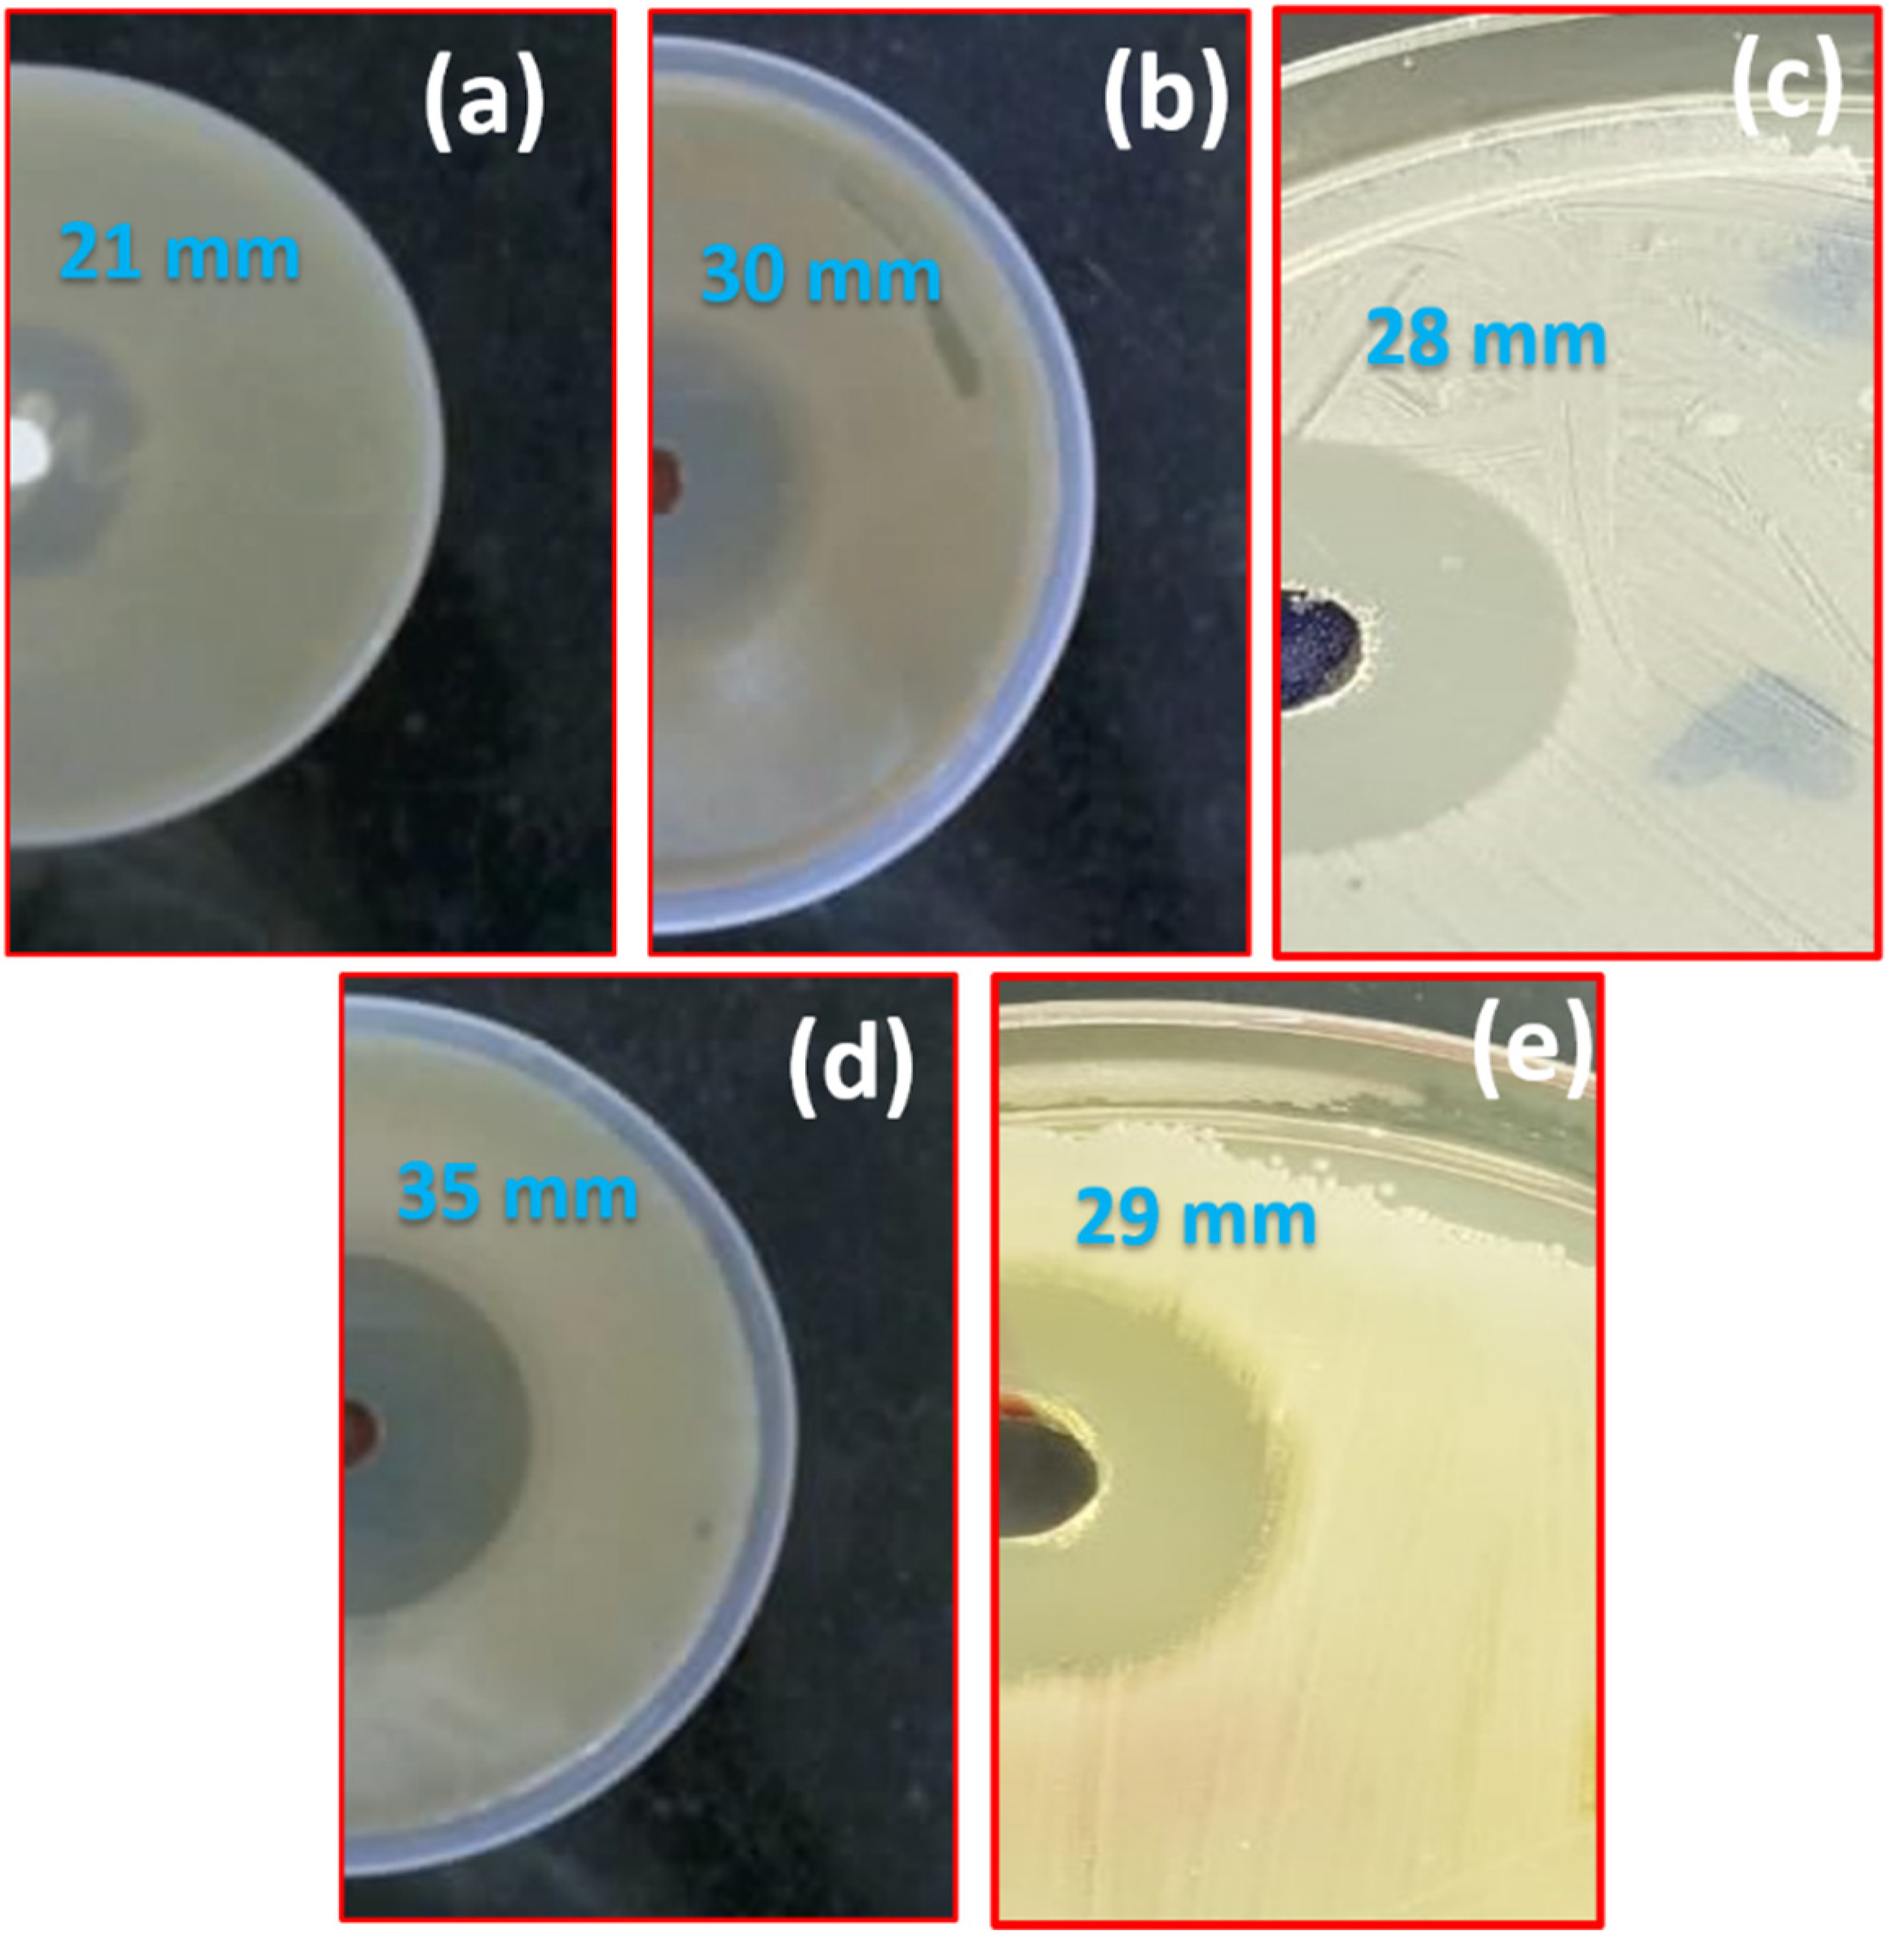
Crystals 11 00666 g004 Crystals 11 00666 g004

Microwave Mediated Fast Synthesis of Silver Nanoparticles and Investigation of Their Antibacterial Activities for Gram-Positive and Gram-Negative Microorganisms
Abstract
1. Introduction
2. Experimental Details
3. Results and Discussion
4. Conclusions
Author Contributions
Funding
Data Availability Statement
Acknowledgments
Conflicts of Interest
References
- Kusaka, T.; Takagi, Y. The Mechanism of a Slime Formation by Microorganisms in a Paper Mill. J. Antibact. Antifungal Agents 1992, 20, 451. [Google Scholar]
- Saito, M. Influence of Particle Size on the Antibacterial Activity of Zinc Oxide. J. Antibact. Antifungal Agents 1993, 21, 17. [Google Scholar]
- Tsunoda, Y.; Egawa, H.; Yuge, O. Preparation and High Bacteriostatic Action of the Activated Carbons Possessing Ultrafine Silver Particles. J. Antibact. Antifungal Agents 1992, 20, 571. [Google Scholar]
- Williams, D.N.; Ehrman, S.H.; Holoman, T.R.P. Evaluation of the Microbial Growth Response to Inorganic Nanoparticles. J. Nanobiotechnol. 2006, 4, 3. [Google Scholar] [CrossRef]
- Gong, P.; Li, H.; He, X.; Wang, K.; Hu, J.; Tan, W.; Zhang, S.; Yang, X. Preparation and Antibacterial Activity of Fe3O4 Ag Nanoparticles. Nanotechnology 2007, 18, 285604. [Google Scholar] [CrossRef]
- Banoee, M.; Seif, S.; Nazari, Z.E.; Fesharaki, P.J.; Shahverdi, H.R.; Moballegh, A.; Moghaddam, K.M.; Shahverdi, A.R. ZnO Nanoparticles Enhanced Antibacterial Activity of Ciprofloxacin against Staphylococcus Aureus and Escherichia Coli. J. Biomed. Mater. Res. B. Appl. Biomater. 2010, 93, 557. [Google Scholar] [CrossRef]
- Gajjar, P.; Pettee, B.; Britt, D.W.; Huang, W.; Johnson, W.P.; Anderson, A.J. Antimicrobial Activities of Commercial Nanoparticles against an Environmental Soil Microbe, Pseudomonas Putida KT2440. J. Biol. Eng. 2009, 3, 9. [Google Scholar] [CrossRef] [PubMed]
- Maliszewska, I.; Sadowski, Z.J. Synthesis and Antibacterial Activity of Silver Nanoparticles. Phys. Conf. Ser. 2009, 146, 012024. [Google Scholar] [CrossRef]
- Jeyaraj, M.; Sathishkumar, G.; Sivanandhan, G. Biogenic Silver Nanoparticles for Cancer Treatment: An Experimental Report. Colloids Surf. B Biointerfaces 2013, 106, 86–92. [Google Scholar] [CrossRef]
- Vijayaraghavan, K.; Nalini, S.P.; Prakash, N.U.; Madhankumar, D. One Step Green Synthesis of Silver Nano/Microparticles Using Extracts of Trachyspermum Ammi and Papaver Somniferum. Colloids Surf. B Biointerfaces 2012, 94, 114–117. [Google Scholar] [CrossRef]
- Magudapathy, P.; Gangopadhyay, P.; Panigrahi, B.K.; Nair, K.G.M.; Dhara, S. Electrical Transport Studies of Ag Nanoclusters Embedded in Glass Matrix. Phys. B 2001, 299, 142. [Google Scholar] [CrossRef]
- Gu, H.; Ho, P.L.; Tong, E.; Wang, L.; Xu, B. Presenting Vancomycin on Nanoparticles to Enhance Antimicrobial Activities. NanoLetter 2003, 3, 1261. [Google Scholar] [CrossRef]
- Iqbal, N.; Kadir, M.R.A.; Malek, N.A.N.N.; Mahmood, N.H.B.; Murali, M.R.; Kamarul, T. Characterization and Antibacterial Properties of Stable Silver Substituted Hydroxyapatite Nanoparticles Synthesized through Surfactant Assisted Microwave Process. Mater. Res. Bull. 2013, 48, 3172–3177. [Google Scholar] [CrossRef]
- Pal, A.; Shah, S.; Devi, S. Synthesis of Au, Ag and Au–Ag Alloy Nanoparticles in Aqueous Polymer Solution. Colloids Surf. A Physicochem. Eng. Asp. 2007, 302, 51. [Google Scholar] [CrossRef]
- Reetz, M.T.; Helbig, W. Size-Selective Synthesis of Nanostructured Transition Metal Clusters. J. Am. Chem. Soc. 1994, 116, 7401. [Google Scholar] [CrossRef]
- Choi, S.H.; Zhang, Y.P.; Gopalan, A.; Lee, K.P.; Kang, H.D. Preparation of Catalytically Efficient Precious Metallic colloids by γ-Irradiation and Characterization. Colloids Surf. A Physicochem. Eng. Asp. 2005, 256, 165. [Google Scholar] [CrossRef]
- Willwohl, H.; Wolfrum, J.; Zumbach, V.; Albers, P.; Seibold, K. Production and Characterization of Highly Dispersed Catalytic Active Platinum and Palladium Powders by Excimer Laser Photolysis. J. Phys. Chem. 1994, 98, 2242. [Google Scholar] [CrossRef]
- Li, Z.; Li, Y.; Qian, X.F.; Yin, J.; Zhu, Z.K. A Simple Method for Selective Immobilization of Silver Nanoparticles. Appl. Surf. Sci. 2005, 250, 109. [Google Scholar] [CrossRef]
- Suslick, K.S.; Choe, S.B.; Cichowlas, A.A. Sonochemical Synthesis of Amorphous Iron. Nature 1991, 353, 414. [Google Scholar] [CrossRef]
- Hayakawa, K.; Iwama, S. Preparation of Ultrafine γ-Fe Particles by Microwave Plasma Processing. Cryst. Growth 1990, 99, 188. [Google Scholar] [CrossRef]
- Ela, S.E.; Cogal, S.; Icli, S. Conventional and Microwave-Assisted Synthesis of ZnO Nanorods and Effects of PEG400 as a Surfactant on the Morphology. Inorg. Chim. Acta 2009, 362, 1855. [Google Scholar]
- Fu-Ken, L.; Pei-Wen, H.; Yu-Cheng, C.; Chu-Jung, K.; Fu-Hsiang, K.; Tieh, C. Formation of Silver Nanorods by Microwave Heating in the Presence of Gold Seeds. Cryst. Growth 2005, 273, 439. [Google Scholar]
- Perez, C.; Pauli, M.; Bazerque, P. Antibiotic Assay by Agar-Well Diffusion Method. Acta Biol. Med. Exper. 1990, 15, 113–115. [Google Scholar]
- Aoki, K.; Chen, J.; Yang, N.; Nagasava, H. Charge-Transfer Reactions of Silver Stearate-Coated Nanoparticles in Suspensions. Langmuir 2003, 19, 9904. [Google Scholar] [CrossRef]
- Nath, S.S.; Chakdar, D.; Gope, G. Synthesis of CdS and ZnS Quantum Dots and Their Applications in Electronics. Nanotrends 2007, 2, 3. [Google Scholar]
- Nath, S.S.; Chakdar, D.; Gope, G.; Avasthi, D.K. Effect of 100 MeV Nickel Ions on Silica Coated ZnS Quantum Dots. Nanoelectron. Optoelectron. 2008, 3, 1. [Google Scholar] [CrossRef]
- Guzman, M.G.; Dille, J.; Godet, S. Synthesis of Silver Nanoparticles by Chemical Reduction Method and Their Antibacterial Activity. World Eng. Technol. 2008, 43, 357–364. [Google Scholar]
- Serra, A.; Filippo, E.; Re, M.; Palmisano, M.; Antisari, M.V.; Buccolieri, A.; Manno, D. Non-Functionalized Silver Nanoparticles for a Localized Surface Plasmon Resonance-Based Glucose Sensor. Nanotechnology 2009, 20, 165501–165508. [Google Scholar] [CrossRef]
- Jose, R.M.; Jose, L.E.; Alejandra, C.; Katherine, H.; Juan, B.K.; Jose, T.R.; Miguel, J.Y. The Bactericidal Effect of Silver Nanoparticles. Nanotechnology 2005, 16, 2346. [Google Scholar]
- Sawai, J.; Shouji, S.; Igarashi, H.; Hashimoto, A.; Kokugan, T.; Shimizu, M.; Kojima, H. Hydrogen Peroxide as an Antibacterial Factor in Zinc Oxide Powder Slurry. Ferment. Bioeng. 1998, 86, 521. [Google Scholar] [CrossRef]
- Kim, J.S.; Kuk, E.; Yu, K.N.; Kim, J.H.; Park, S.J.; Lee, H.J.; Kim, S.H.; Park, Y.K.; Park, Y.H.; Hwang, C.Y. Antimicrobial Effects of Silver Nanoparticles. Nanomed. Nanotechnol. Biol. Med. 2007, 3, 95–101. [Google Scholar] [CrossRef] [PubMed]
- Gangadoo, S.; Elbourne, A.; Medvedev, A.E.; Cozzolino, D.; Truong, Y.B.; Crawford, R.J.; Wang, P.Y.; Truong, V.K.; Chapman, J. Facile Route of Fabricating Long-Term Microbicidal Silver Nanoparticle Clusters against Shiga Toxin-Producing Escherichia Coli O157: H7 and Candida Auris. Coatings 2020, 10, 28. [Google Scholar] [CrossRef]
- Goga, M.; Baláž, M.; Daneu, N.; Elečko, J.; Tkáčiková, Ľ.; Marcinčinová, M.; Bačkor, M. Biological Activity of Selected Lichens and Lichen-Based Ag Nanoparticles Prepared by a Green Solid-State Mechanochemical Approach. Mater. Sci. Eng. C 2021, 119, 111640. [Google Scholar] [CrossRef] [PubMed]
- Gangadoo, S.; Nguyen, H.; Rajapaksha, P.; Zreiqat, H.; Latham, K.; Cozzolino, D.; Chapman, J.; Truong, V.K. Inorganic Nanoparticles as Food Additives and their Influence on the Human Gut Microbiota. Environ. Sci. Nano 2021. [Google Scholar] [CrossRef]

Publisher’s Note: MDPI stays neutral with regard to jurisdictional claims in published maps and institutional affiliations. |
© 2021 by the authors. Licensee MDPI, Basel, Switzerland. This article is an open access article distributed under the terms and conditions of the Creative Commons Attribution (CC BY) license (https://creativecommons.org/licenses/by/4.0/).
Share and Cite
Ahmed, F.; AlOmar, S.Y.; Albalawi, F.; Arshi, N.; Dwivedi, S.; Kumar, S.; Shaalan, N.M.; Ahmad, N. Microwave Mediated Fast Synthesis of Silver Nanoparticles and Investigation of Their Antibacterial Activities for Gram-Positive and Gram-Negative Microorganisms. Crystals 2021, 11, 666. https://doi.org/10.3390/cryst11060666
Ahmed F, AlOmar SY, Albalawi F, Arshi N, Dwivedi S, Kumar S, Shaalan NM, Ahmad N. Microwave Mediated Fast Synthesis of Silver Nanoparticles and Investigation of Their Antibacterial Activities for Gram-Positive and Gram-Negative Microorganisms. Crystals. 2021; 11(6):666. https://doi.org/10.3390/cryst11060666
Chicago/Turabian StyleAhmed, Faheem, Suliman Yousef AlOmar, Fadwa Albalawi, Nishat Arshi, Sourabh Dwivedi, Shalendra Kumar, Nagih Mohammed Shaalan, and Naushad Ahmad. 2021. "Microwave Mediated Fast Synthesis of Silver Nanoparticles and Investigation of Their Antibacterial Activities for Gram-Positive and Gram-Negative Microorganisms" Crystals 11, no. 6: 666. https://doi.org/10.3390/cryst11060666
APA StyleAhmed, F., AlOmar, S. Y., Albalawi, F., Arshi, N., Dwivedi, S., Kumar, S., Shaalan, N. M., & Ahmad, N. (2021). Microwave Mediated Fast Synthesis of Silver Nanoparticles and Investigation of Their Antibacterial Activities for Gram-Positive and Gram-Negative Microorganisms. Crystals, 11(6), 666. https://doi.org/10.3390/cryst11060666

